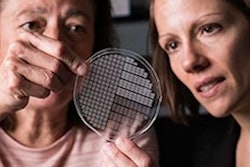

The U.S. National Institute of Dental and Craniofacial Research (NIDCR) has awarded a grant to Marquette University School of Dentistry and the University of Wisconsin-Madison worth potentially up to $4.2 million over seven years. The institutions will use the funds to investigate how to prevent no-show dental appointments in underserved populations.
Marquette will receive $337,401 in the first year of the grant plus $1.3 million for a five-year clinical trial phase if project milestones are met, according to the university. Overall, the grant has the potential to be worth $4.2 million over all seven years.